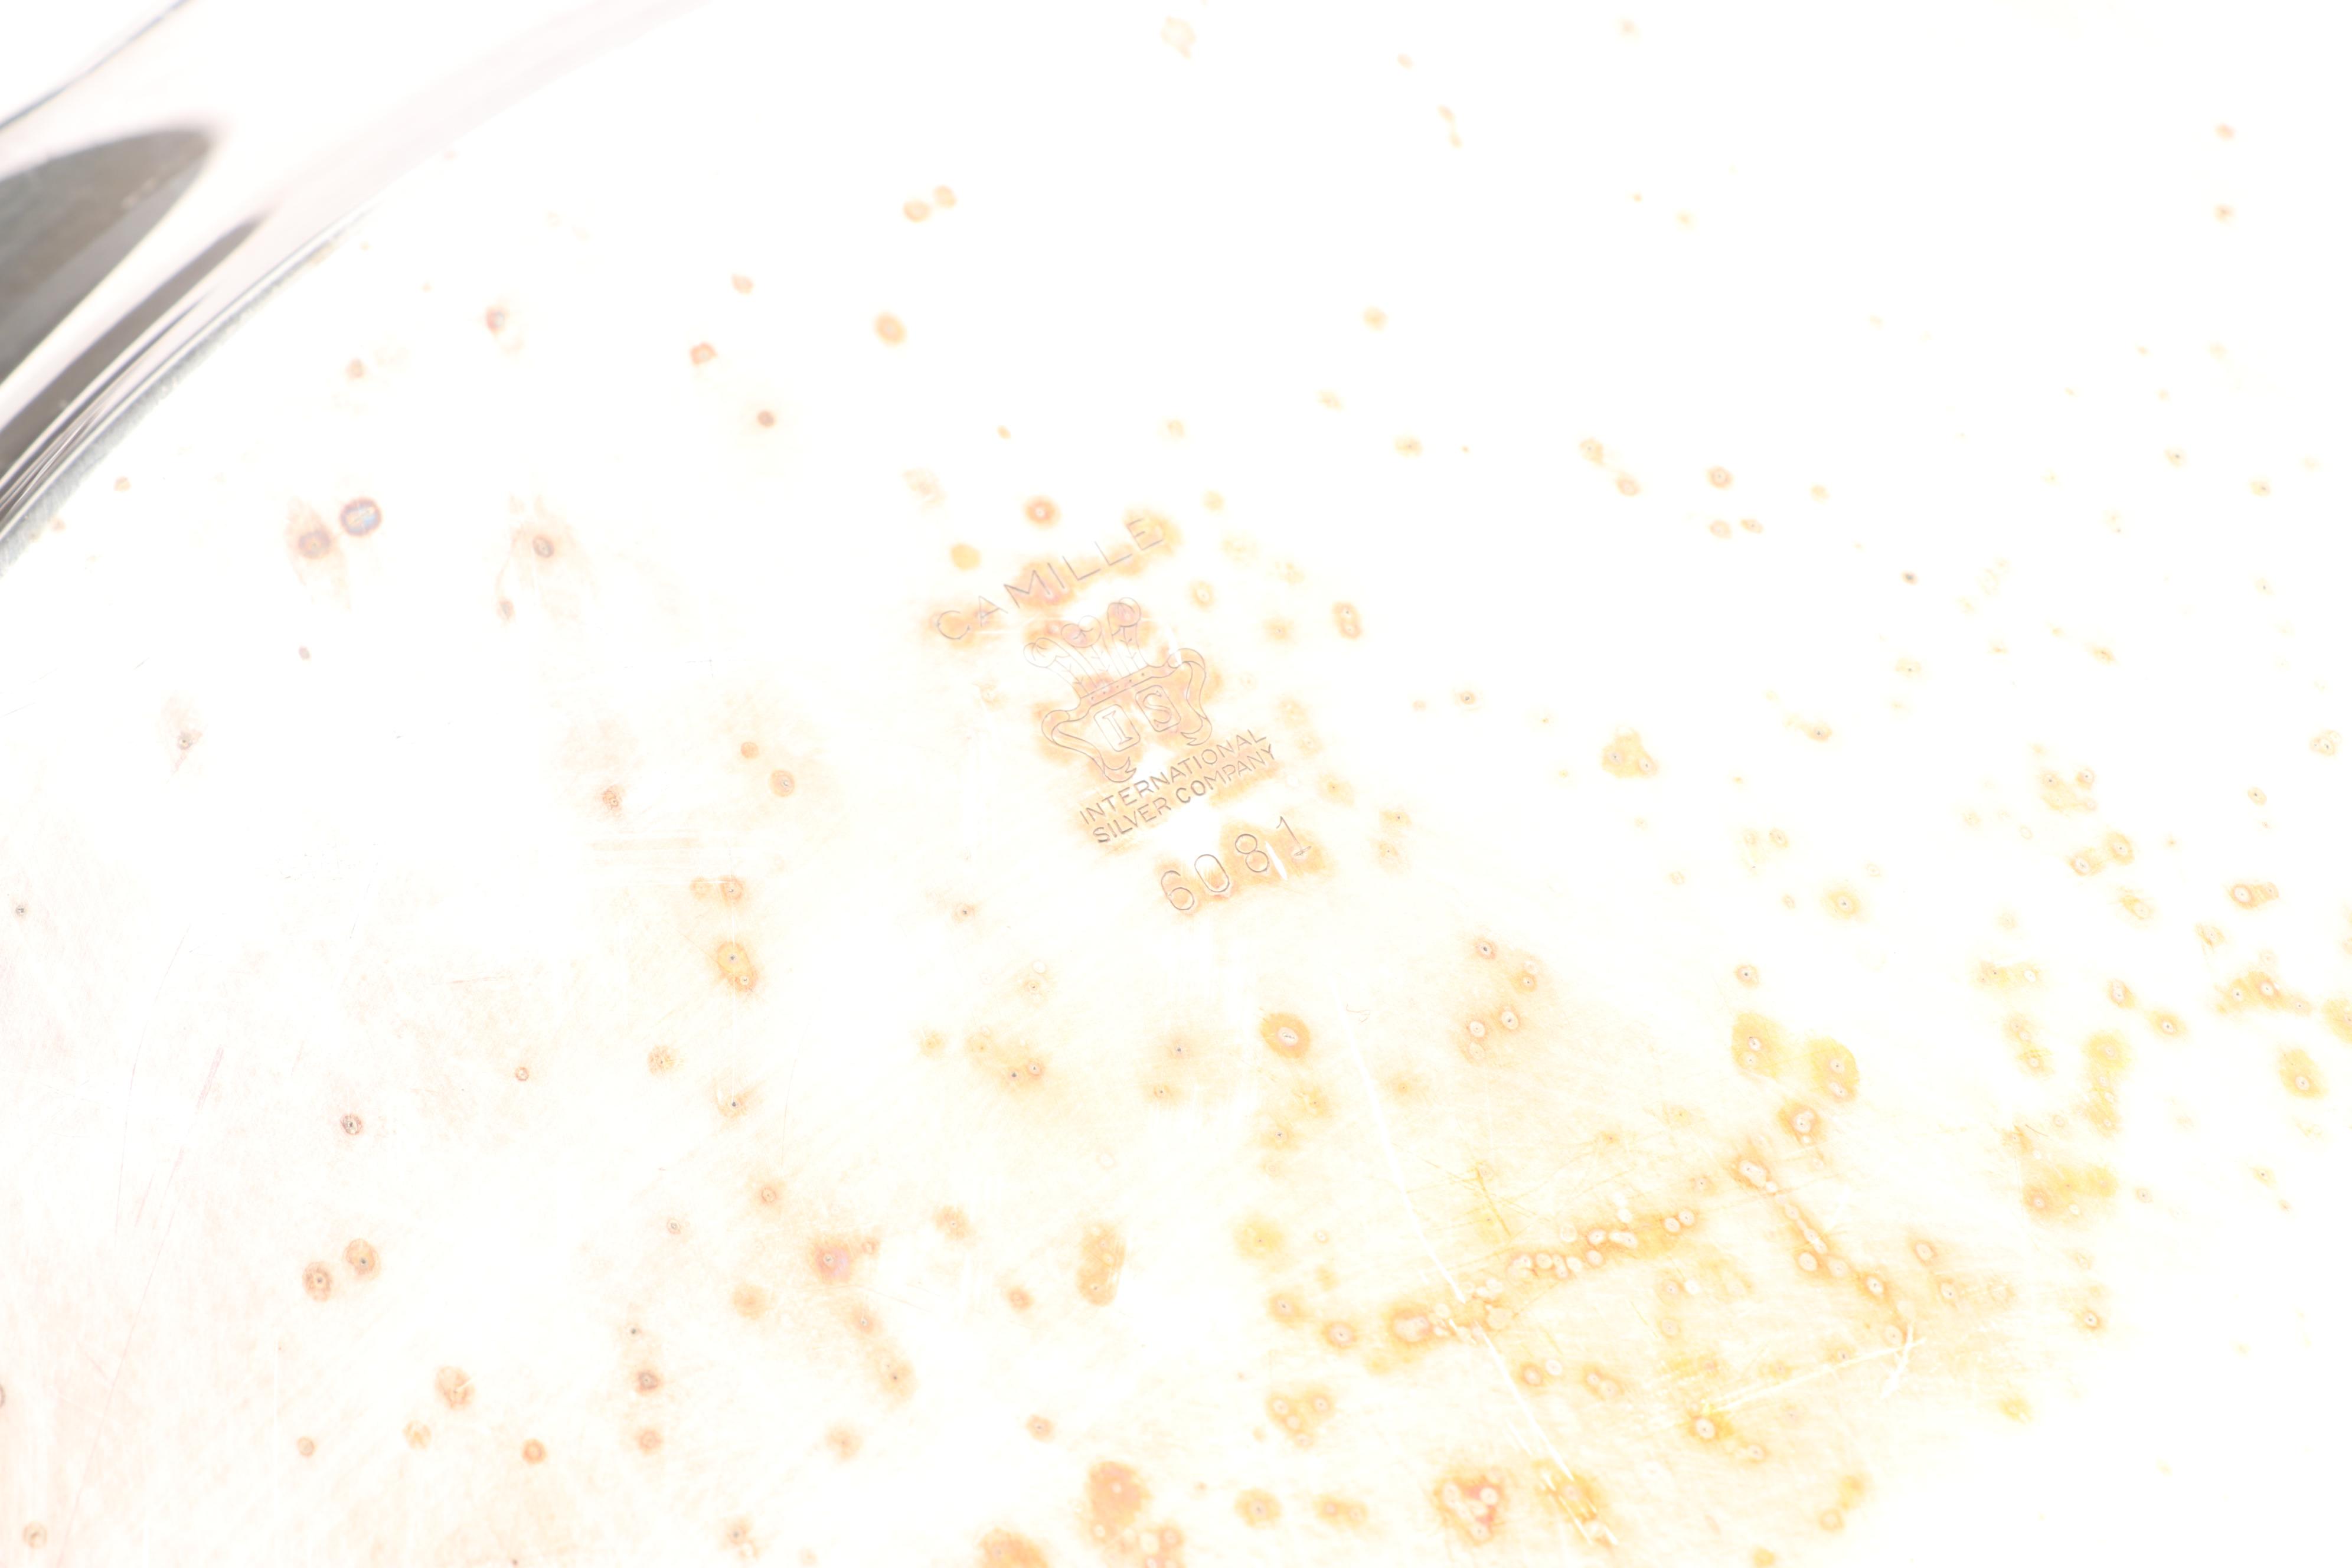
International Silver Co. "Camille" Silver Plate Tea and Coffee Service Set

View all items from Fine China, Traditional Furnishings and Coins sale
International Silver Co. "Camille" Silver Plate Tea and Coffee Service Set
Item Details
| Brand | International Silver Co. |
| Materials | Silver Plate |
| Marks | Maker’s Mark, Pattern, Shape Number |
| Period | Late 20th Century |
| Origin | United States |
| Pattern | Camille |
| Number of Items | 5 |
Condition
- moderate tarnishing; surface scratches, especially to undersides and the topside of the waiter tray; some water marks and spotting.
Dimensions
24.0" W x 15.0" H x 1.0" D
- measurements of the waiter tray.
Item #
18CLT509-069